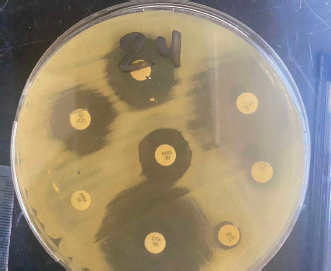

| Research Article | ||
Open Vet. J.. 2025; 15(4): 1607-1614 Open Veterinary Journal, (2025), Vol. 15(4): 1607-1614 Research Article A comparative study to investigate foodborne pathogenic bacteria in fresh and imported frozen Scomber japonicus (Houttuyn, 1782) in Tripoli, LibyaNouralhuday Ali Altayr1, Khawla Khirallah Bukha2, Shahrazad Ali Eteer3*, Najat Ali El-magrahi1, Areeg M. Elhom1, Rayan A. Elmaloul1 and Salma F. Fakar11Department of Microbiology and Immunology, Faculty of Pharmacy, University of Tripoli, Tripoli, Libya 2Department of Poultry and Fish Diseases, Faculty of Veterinary Medicine, University of Tripoli, Tripoli, Libya 3Department of Medicinal and Pharmaceutical Chemistry, Faculty of Pharmacy, University of Tripoli, Tripoli, Libya *Corresponding Author: Shahrazad Ali Eteer. Department of Medicinal and Pharmaceutical Chemistry, Faculty of Pharmacy, University of Tripoli, Tripoli, Libya. Email: sh.eteer [at] uot.edu.ly Submitted: 27/11/2024 Accepted: 03/03/2025 Published: 30/04/2025 © 2025 Open Veterinary Journal
AbstractBackground: The bacterial load in fresh and frozen fish is a major public health concern. Aim: This study aimed to determine the prevalence of human pathogenic foodborne bacteria and their antibiotic resistance profiles in fresh and frozen chub mackerel (Scomber japonicus) fish. Methods: A total of 60 samples of fresh and imported frozen chub mackerel (Scomber japonicus) were randomly collected from anglers on boats in the Bab-Albahr market in Tripoli, Libya. Bacterial isolation from muscles was performed using a suitable culture media. Biochemical identification of the isolated bacteria was performed using the API 20E and its antibiogram. Results: The total number of bacterial isolates from 30 fresh samples was 53, and from 30 imported frozen samples was 26. The most frequently occurring species in fresh fish were Vibrio cholera (32%), Proteus mirabilis (26.4%), Vibrio alginolyticus (22.6%), and Escherichia coli (18.8%), while in frozen fish were E. coli (50%), Citrobacter freund (23.07%), Klebsiella pneumoniae (15.3%), and V. alginolyticus (11.5%). The isolates exhibited high resistance to β-lactam antibiotics. Conclusion: The microbial assessment of chub mackerel (Scomber japonicus) provides insights into the sanitary conditions along the Tripoli coast. In addition, the results of the present study indicate that imported frozen fish sold in Tripoli’s fish markets could pose a public health threat. This research is considered a preliminary microbial assessment of S. japonicus contamination in the Tripoli market and along the Tripoli Coast. The incidence of S. aureus infections emphasized the presence of an issue in husbandry practices, insufficient adherence to basic hygiene protocols, and the random use of antibiotics. Keywords: Phylogenetic analysis tree, S. aureus, Sheep milk, Virulence factors. IntroductionSeafood is a globally popular food because it is rich in protein content and affordable price (Muhammad et al., 2020). It remains one of the most cost-effective sources of protein. Moreover, the muscles of fish contain a wide range of essential nutrients necessary for human health (Sarker et al., 2021). Raw or undercooked seafood exposes humans to many types of bacterial pathogens (Novoslavskij et al., 2016; Mumbo et al., 2023). Most bacteria associated with fish are native to aquatic environments and survive independently from their hosts (Abodaia et al., 2020). Fish can harbor pathogenic bacteria. These bacteria can enter fish via various pathways, such as during cooking, improper handling, poor preservation, and inadequate sanitation. In addition, fish caught in polluted marine environments contaminated with hazardous heavy metals and chemicals can have harmful impacts on public health when consumed (Elsharif et al., 2018). Heavy metals such as cadmium, lead, and mercury can accumulate in fish tissues and transfer to the human body, leading to serious health damage (Nyarko et al., 2023). In addition, chemical contamination can enhance the growth of harmful algae, increasing the risk of foodborne diseases (Abera and Adimas, 2024). Pathogenic bacteria can colonize the gills and skin of fish due to ongoing exposure to polluted marine environments, whereas the digestive tract can become infected via exposure to polluted water or contaminated feed. In healthy fish, the internal organs and muscles remain sterile (Novoslavskij et al., 2016). On the other hand, the detection of bacteria in fish often serves as an indicator of the state and health of the marine environment. Bacterial analysis is commonly used as an environmental indicator of pollution levels (Novoslavskij et al., 2016). One significant concern with eating raw or undercooked seafood is the potential presence of foodborne pathogens in aquatic environments (Abodaia et al., 2020; Muhammad et al., 2020). The microbial quality of seafood is a significant public health concern worldwide. Globally, foodborne illnesses due to bacterial contamination cause more than 600 million cases annually, with 420000 resulting in fatalities (Muhammad et al., 2020; Mumbo et al., 2023). Listeria monocytogenes, salmonella, Yersinia, campylobacter, and Escherichia coli, as identified by the European Food Safety Authority, play a major role in causing global foodborne outbreaks (Authority et al., 2015). They are responsible for the development of foodborne diseases in humans (Mumbo et al., 2023). Globally, the consumption of frozen fish has increased (Eldaly et al., 2015). Freezing of fish can destroy some bacteria, but sometimes other species, such as Aeromonas spp, E. coli, Vibrio spp, and Clostridium botulinum (Ob et al., 2012), remain alive and proliferate again when the fish is thawed (Eze et al., 2011). Many studies have reported that the types and quantity of foodborne pathogenic bacteria present in frozen fish depend on many factors, such as the environment in which fish live, the source of the fish, contamination on the fishing boat, freezing conditions during storage, or contamination handlers of anglers and sellers in markets (Eze et al., 2011; Sheng and Wang, 2021). Widespread antimicrobial drug use in healthcare and agriculture has led to a significant increase in the proliferation of antibiotic resistance in the environment (Zanetti et al., 2001; Abodaia et al., 2020). Moreover, fish have the potential to contribute to the dissemination of antibiotic resistance genes to various bacterial species via horizontal gene transfer, which poses a potential risk to human health (Mumbo et al., 2023). In Libya, coastal waters are the primary pollutant source, particularly untreated urban wastewater. This contamination may contribute to the persistence and spread of foodborne pathogens in fish. In addition, there is a lake where comprehensive research has been conducted on the presence of foodborne pathogens in imported frozen fish in Libya. The present study contributes to the growing database of bacterial contamination in seafood, particularly in the context of North Africa. Therefore, the objectives of the present study were to isolate and identify the human pathogenic foodborne bacteria from fresh and imported frozen chub mackerel (Scomber japonicus) samples sold in Libya. Also, to detect the antibiotic susceptibility patterns of the isolated bacteria and compare the prevalence of the isolated bacteria and their antibiotic resistance profiles between fresh and imported frozen chub mackerel fish. Materials and MethodsFish samplingA total of 60 samples were randomly collected in the mornings (between 7 am and 9 am) from 30 fresh fish of chub mackerel (Scomber japonicus) from the angler on the boat after catching and 30 imported frozen fish collected from Bab-Albahr market in Tripoli, Libya, throughout the period from March to August 2024. In the present study, random sampling was adopted as a practical strategy to ensure an unbiased selection of Scomber japonicus samples. Fish samples were kept on crushed ice in an isothermal box and transferred to the Laboratory of Microbiology, Faculty of Pharmacy, University of Tripoli, Tripoli, Libya. Sample processing and bacterial isolationFish were flushed with 70% ethanol to eliminate any external contaminants prior to bacteriological examination. The muscles of the fish were cut into small pieces using sterile scissors. Sample preparation of all fish bodies was performed using the method described by Elsharif et al. (2018). Approximately 10 g of the fish sample was obtained from the head, middle, and tail regions by cutting with a sterile knife. The cut samples were crushed into small pieces using a sterile mortar with approximately 10 ml of sterile water. From the crushed sample, 1-ml aliquot volume was measured and homogenized in a clean, dry sterile beaker containing 9 ml of distilled water, yielding a 1:10 dilution. Isolation of bacterial speciesTwo loops from each sample were suspended in two tubes of a nutrient broth and alkaline peptone water and then incubated at 37°C for 24 hours. A loop full from each suspension of a nutrient broth was inoculated onto plates of MacConkey and Nutrient agar to isolate members of Enterobacteriaceae and other gram-negative bacilli. The loop full of the suspension of alkaline peptone water was inoculated onto plates of TCBS agar (Thiosulfate Citrate Bile Salts Sucrose Agar) to isolate Vibrio bacteria. All dishes were incubated in the incubator at 37°C for 24 hours. Biochemical identification of isolated bacteriaThe isolated bacteria were identified by gram staining of different types of culture. Biochemical tests are also important for the identification of E. coli, the oxidase test for Vibrio spp, and the TSI test to differentiate Enterobacteriaceae. According to previous tests, the API 20E was incubated at 37°C for 18–24 hours. The API 20E is a standard procedure for identifying Enterobacteriaceae and other gram-negative rod bacteria using 23 miniaturized biochemical tests and a database. The device consists of 20 microtubes containing dehydrated substrate, which were inoculated with a bacterial suspension that reconstitutes the media. Color changes during incubation that were either spontaneous or revealed by the addition of a reagent. Table 1. Antibiotic discs and their concentrations were used in the study.
Antibiotic sensitivity testThe susceptibility of the isolated bacteria to antimicrobial agents was determined by (Kirby-Bauer technique). Each bacterial strain was suspended in sterile normal saline (0.85%) to a turbidity level matching that of the 0.5 McFarland turbidity standard. Muller–Hinton agar plates were surface swabbed with tested bacteria, and then the selected antibiotic disks were dispensed onto the inoculated agar surface. The plates were then incubated at 37°C for 18–24 hours. After overnight incubation, the bacterial growth around each disk was observed, and the zone was then measured in millimeters. The tested isolates were characterized as sensitive, intermediate, or resistant based on the size of the inhibition zone around each disk, according to the guidelines of the Clinical and Laboratory Standards Institute. The results were interpreted in accordance with the standards of the Clinical and Laboratory Standards Institute. The antibiotics used in this study are listed in Table 1. ResultsPrevalence of gram-negative bacteria in fresh chub mackerel (Scomber japonicus)The study showed that the total number of bacterial isolates from 30 fresh samples was 53, and all the isolates were gram-negative bacteria. Two species were detected in 24 out of 30 samples (80%). The most frequently isolated organisms were Vibrio cholera (32%) followed by Proteus mirabilis (26.4%), Vibrio alginolyticus (22.6%), and E. coli. (18.8%) as shown in Figures 1 and 2. The bacteria isolated from Scomber japonicus are summarized in Table 2. Antibiotic resistance patternAll identified isolates were tested for susceptibility to various antibiotics according to guidelines set by CLSI. The antibiotic sensitivity patterns of the gram-negative bacteria isolated from fresh Scomber japonicus are summarized in Table 3. The antibiogram results of the tested isolates showed different resistance to eight types of antibiotics. The majority of V. cholera were resistant to amoxicillin, amoxicillin-clavulanic acid, and ceftriaxone, but less resistant to other antibiotics. Similarly, V. alginolyticus was found to be resistant to amoxicillin, amoxicillin-clavulanic acid, and ceftriaxone, while being less resistant to other tested antibiotics. However, both E. coli and P. mirabilis were resistant to all tested antibiotics, with the exception of levofloxacin, which was sensitive to antibiotics Figure 3. Prevalence of gram-negative bacteria in imported frozen chub mackerel (Scomber japonicus)The results showed that the total number of bacterial isolates from 30 samples was 26. The bacteria isolated from S. japonicus are summarized in Table 4 in which all the isolates identified as gram-negative bacteria. During the bacterial isolation from Scomber japonicus, two of the 23 fish samples (8.6%) tested positive for multiple bacterial species. The results revealed that 76.6% (23/30) of S. japonicus samples yielded bacterial growth. The most frequently isolated organisms were E. coli (50%) followed by Citrobacter freundii (23.07%), Klebsiella pneumonia (15.3%), and finally V. alginolyticus (11.5%). Antibiotic resistance patternAll identified isolates were tested for susceptibility to various antibiotics according to guidelines set by CLSI. The antibiotic sensitivity patterns of the gram-negative bacteria isolated from S. japonicus are summarized in Table 5. The antibiogram results of the tested isolates showed different resistance to eight types of antibiotics. The majority of isolates of E. coli were resistance to amoxicillin, amoxicillin-clavulanic acid, and erythromycin, but less resistant to other antibiotics. Similarly, higher resistance of V. alginolyticus has been reported against amoxicillin, amoxicillin-clavulanic acid, and erythromycin, whereas they have the same resistance to tetracycline, chloramphenicol, levofloxacin, ceftriaxone, and imipenem. Both K. pneumonia and C. freundii were resistant to all tested antibiotics Figure 4. DiscussionFish can host different types of foodborne pathogens within their bodies and on their surfaces. The load of foodborne pathogens in seafood products can result from the aquatic environment where the fish are harvested, hygienic conditions, storage, or transportation before freezing processes (Mmuoh, 2023). Seafood is a vital source of nutritional components for humans. Nevertheless, poorly handled and prepared fish can put consumers at risk of infection by foodborne pathogens (Abodaia et al., 2020). In this study, the total number of bacteria isolated from fresh chub mackerel fish was higher than that isolated from imported frozen chub mackerel fish (53 vs. 26, respectively). This variation in the number of isolated bacteria between fresh and frozen fish could be attributed to the freezing, where the crystals of ice are located within fish tissues, leading to the destruction of bacterial cells. However, some bacterial cells may survive during the freezing process but remain inactive and unable to proliferate. In contrast, the bacterial cells in fresh fish remain alive and proliferate under favorable conditions that are suitable for their normal growth (Duarte et al., 2020). Similar results have been reported by Pohoroo and Ranghoo-Sanmukhiya (2017) who were found that the total bacterial count of frozen fish was lower than that of fresh fish due to the inhibitory effects of the freezing process on bacterial growth. On the contrary, El-Dengawy et al. (2017) found that the number of proteolytic bacteria increased over the storage period, particularly if the thawing process was performed incorrectly. Accordingly, this study supported the idea that freezing processes may reduce the overall bacterial load, resulting in frozen fish having better microbiological quality compared to fresh fish.
Fig. 1. (A) Indole test for the bacterial isolate. A positive result is indicated by the formation of a distinct red layer on the surface of the medium. (B) Oxidase test result for the bacterial isolate. A positive result is indicated by the development of a dark purple coloration. (C) Catalase test result for the bacterial isolate. A positive result is indicated by the appearance of gas bubbles. All foodborne pathogenic bacteria isolated from fresh chub mackerel fish were gram-negative. Upon isolation of bacteria from fish samples, we found that 24 out of 30 fish contained two bacterial species. The most frequently occurring species were V. cholera (32%), P. mirabilis (26.4%), V. alginolyticus (22.6%), and E. coli (18.8%). The presence of high levels of Vibrio cholera could be a result of the contamination of the seawater of the Tripoli coast in which the fish live or from which they were harvested. These results were consistent with those reported by Abioye et al. (2023), who found V. cholera and V. mimicus to be significantly more abundant in seafood collected in South Africa. In contrast, conflicting results have been reported by Abodaia et al. (2020), who found that the most predominant species of isolated Vibrio from fresh finfish sold in Tripoli fish markets was V. fluvialis. The presence of P. mirabilis and E. coli isolates from fresh chub mackerel fish could be explained by fecal contamination in the seawater of the Tripoli coast or by unsanitary practices during catching, handling, or transportation of fish.
Fig. 2. Identification of the bacterial isolate using the API 20E system. Various wells exhibited distinct color changes for isolates. Table 2. Number of gram-negative bacteria isolated from fresh fish samples (Scomber japonicas).
Table 3. Antibiotic sensitivity of bacteria isolated from fresh fish.
Fig. 3. The antibiogram results showed varying resistance patterns among the tested isolates. Vibrio cholerae and Vibrio alginolyticus were highly resistant to amoxicillin, amoxicillin-clavulanic acid, and ceftriaxone but showed lower resistance to other antibiotics. Escherichia coli and Proteus mirabilis exhibited resistance to all tested antibiotics except levofloxacin, to which they remained sensitive. Table 4. Percentage of gram-negative bacteria isolated from imported frozen fish samples (Scomber japonicus).
Table 5. Antibiotic sensitivity of bacteria isolated from imported frozen fish.
Fig. 4. The antibiogram results showed Escherichia coli and Vibrio alginolyticus exhibited high resistance to amoxicillin, amoxicillin-clavulanic acid, and erythromycin, while showing similar resistance to tetracycline, chloramphenicol, levofloxacin, ceftriaxone, and imipenem. Klebsiella pneumoniae and Citrobacter freundii were resistant to all tested antibiotics. The results in Table 3 revealed the antibiotic sensitivity pattern of the gram-negative bacteria isolated from fresh chub mackerel fish, which were found to have different resistance against commonly used antibiotics for treating various bacterial infections. These results indicate that the seawater on the Tripoli coast, where fish live, may be contaminated by the wastewater sewage of agriculture and industry into the marine environment. Similar results were reported by Bukha et al. (2023), who found that the isolated Vibrio spp. from fish were resistant to amoxicillin/clavulanate. In addition, the findings of this study agreed with those reported by Abodaia et al. (2020), who found that all Vibrio spp. showed high resistance to amoxicillin, amoxicillin/ clavulanic, oxytetracycline, cephalothin, cloxacillin, and vancomycin. In the current study, the results in Table 4 revealed the most frequent organisms isolated from imported frozen chub mackerel fish were E. coli (50%) followed by C. freundii (23.07%), K. pneumonia (15.3%), and V. alginolyticus (11.5%). The results illustrated that E. coli was the most frequently isolated isolate from frozen fish, whereas Vibrio spp. was the most frequently isolated from fresh fish. This difference could be attributed to the freezing process, which can create an extremely cold environment where most bacteria are unable to survive and grow. However, some bacteria, such as E. coli, can accommodate and remain alive but inactive during freezing processes. If the fish were exposed to fecal contamination before freezing, E. coli may remain in the frozen fish (Abioye et al., 2023). In contrast, Vibrio spp. is unable to survive under freezing conditions such as 20°C for a long time. Generally, freezing at 20°C is lethal for Vibrio spp (Al-Garadi et al., 2024). Therefore, it was expected to be present at higher percentages in fresh fish. The antibiotic sensitivity pattern of the gram-negative bacteria isolated from fresh chub mackerel fish showed different resistance against commonly used antibiotics Table 5. The results were consistent with those reported by Elhadi (2016), where the findings showed the highest rates of antibiotic resistance patterns were observed in isolated E. coli from imported frozen fish. The multi-drug-resistant pattern of isolated E. coli from frozen fish can lead to difficulties in treating patients and increase the risk of recurrent infection. In addition, C. freundii and K. pneumonia can cause failure in treating urinary and respiratory infections. The results of this study revealed that both types of the most isolated bacteria (Vibrio spp and E. coli) from fresh and frozen fish exhibited resistance to the β- lactam antibiotics. This may indicate a prevalent problem associated with antibiotic resistance. In addition, bacterial resistance to the β- lactam antibiotics may result from the widespread use of antibiotic drugs in aquaculture or the marine ecosystem, leading to the spread of antibiotic-resistant genes among various bacteria or during the processing stages of fish storage. ConclusionThe isolation of three human pathogenic bacteria, including Proteus, Vibrio, and E. coli, from fresh and frozen chub mackerel fish from the Tripoli coast indicated significant fecal contamination. This is likely due to the discharge of untreated sewage. Fish act as reservoirs of human pathogens, posing a potential health risk to consumers and causing illness in susceptible humans. This will help us understand the level of bacterial contamination in fresh fish and thus identify the most common species of bacteria. In addition, the isolation of these pathogens from imported frozen chub mackerel fish indicates that fish available in the fish markets of Tripoli may pose a public health threat. Furthermore, the presence of antibiotic-resistant bacteria in fresh and frozen fish further complicates the issue because it may hinder the effective treatment of infections. The current study provides essential insights into the bacterial profile and antibiotic resistance pattern of fresh and frozen Scomber japonicus fish in Tripoli, Libya, with significant consequences for food safety, environmental monitoring, and public health. To mitigate these public health risks, regular inspections and strict enforcement of regulations are imperative for fish markets and restaurants in Libya to ensure the quality and safety of seafood. AcknowledgmentsWe would like to thank SAE for his valuable supervision and guidance throughout this work as the corresponding author. Also, we would like to express our gratitude to the Department of Microbiology and Immunology, Faculty of Pharmacy, University of Tripoli, for their support and assistance in this study. Conflict of interestThe authors declare that they have no commercial or financial relationships that could be construed as a potential conflict of interest. Authors’ contributionsNAA and KKB: designed the study. KKB: wrote the manuscript. NAA, NAE, AME, RAE, and SFF conducted the experiment. SAE: supervised the study and revised the manuscript. All authors have read, reviewed, and approved the final version of the manuscript. ReferencesAbera, B.D. and Adimas, M.A. 2024. Health benefits and health risks of contaminated fish consumption: current research outputs, research approaches, and perspectives. Heliyon, 10(13), e33905. Abioye, O.E., Nontongana, N., Osunla, C.A. and Okoh, A.I. 2023. Antibiotic resistance and virulence genes profiling of vibrio cholerae and vibrio mimicus isolates from some seafood collected at the aquatic environment and wet markets in eastern cape province, south africa. PLoS One, 18(8), e0290356. Abodaia, E.R., Eshamah, H.L. and Naas, H.T. 2020. Prevalence of antibiotic resistant vibrio spp. In finfish sold in tripoli fish markets, libya. North Afr. J. Food Nutr. Res. 4(8), 309–317. Al-Garadi, M.A., Aziz, R.N., Almashhadany, D.A., Al Qabili, D.M.A. and Abdullah Aljoborey, A.D. 2024. Validity of cold storage and heat treatment on the deactivation of vibrio parahaemolyticus isolated from fish meat markets. Ital. J. Food Saf. 13(1), 11516; doi: 10.4081/ijfs.2024.11516 Authority, E.F.S., Prevention, E.C.F.D. and Control. 2015. The european union summary report on trends and sources of zoonoses, zoonotic agents and food-borne outbreaks in 2013. EFSA. J. 13(1), 3991. Bukha, K.K., Mahgiubi, S.A., Elbahi, A.M., Sharif, E.A., Showehdi, M.L., Ahmed, M.O., Kammon, A.M. and Abouzeed, Y.M. 2023. Pathological lesions associated with vibrio infection in atlantic horse mackerel (trachurus trachurus l., 1758) from the western coast of tripoli, libya. Open Vet. J. 13(3), 327–336. Duarte, A.M., Silva, F., Pinto, F.R., Barroso, S. and Gil, M.M. 2020. Quality assessment of chilled and frozen fish” mini review. Foods 9(12), 1739. El-Dengawy, R., Sharaf, A., El-Kadi, S., Mahmoud, E.A. and Baidoon, E.S. 2017. Effect of frozen storage on the chemical, physical and microbiological quality of imported mackerel (Scomber scombrus). J. Food Dairy Sci. 8(7), 287–293. Eldaly, E.A., Elshater, M.A., Hussein, M.A. and Sharaf Eldin, A.M. 2015. Assessment of food poisoning bacteria in some frozen fish and fish products. Zagazig Vet. J. 43(3), 46–52. Elhadi, N. 2016. Prevalence of extended-spectrum-β-lactamase-producing escherichia coli in imported frozen freshwater fish in eastern province of saudi arabia. Saudi J. Med. Sci. 4(1), 19–25. Elsharif, M., Ali, M., Saleh, F. and Abokhras, A. 2018. Isolation and identification of pathogenic bacteria from domestic retail fish market at zliten city, libya. Libyan J. Sci. Technol. 8(1), 2231. Eze, E., Echezona, B. and Uzodinma, E. 2011. Isolation and identification of pathogenic bacteria associated with frozen mackerel fish(scomber scombrus) in a humid tropical environment. Afr. J. Agric. Res. 6(8), 1947–1951. Mmuoh, C. 2023. Determination of heavy metals and microbiological contamination of frozen mackerel (Scomber scombrus) sold in eke-awka market, awka, anambra state, nigeria. Awka, Nigeria: E-Proceedings of the Faculty of Agriculture International Conference (FAIC) Muhammad, K., Kiman, S.H., Muhammad, K., Jesse, I. and Mohammed, S. 2020. Isolation and identification of pathogenic bacteria from fresh fish organs. Int. Res. J. Adv. Sci. 1(2), 42–46. Mumbo, M.T., Nyaboga, E.N., Kinyua, J., Muge, E.K., Mathenge, S.G., Muriira, G., Rotich, H., Njiraini, B. and Njiru, J.M. 2023. Prevalence and antimicrobial resistance profile of bacterial foodborne pathogens in nile tilapia fish (Oreochromis niloticus) at points of retail sale in nairobi, kenya. Front. Antibiot. 2, 1156258. Novoslavskij, A., Terentjeva, M., Eizenberga, I., Valciņa, O., Bartkevičs, V. and Bērziņš, A. 2016 Major foodborne pathogens in fish and fish products: a review. Ann. Microbiol. 66, 1–15. Nyarko, E., Boateng, C.M., Asamoah, O., Edusei, M.O. and Mahu, E. 2023. Potential human health risks associated with ingestion of heavy metals through fish consumption in the gulf of guinea. Toxicol. Rep. 10, 117–123. Ob, A., Po, O., Hc, I.A. and Okonko, I. 2012. Benefits, public health hazards and risks associated with fish consumption. N Y Sci. J. 5, 33–61. Pohoroo, A. and Ranghoo-Sanmukhiya, V. 2017. Food-borne bacterial load in fresh and frozen fish sold in mauritius. Int. Food Res. J. 24(5), 2193–2200. Sarker, R., Alam, M., Hossain, M.A., Hamid, A., Rabbni, A., Islam, R. and Badiruzzaman, M. 2021. Isolation and identification of pathogenic bacteria from baime fish (Mystus armatus) and evaluation of antibiotic susceptibility. Eur. J. Med. Health Sci. 3(6), 136-146. doi: 10.34104/ejmhs.021.01360146 Sheng, L. and Wang, L. 2021. The microbial safety of fish and fish products: recent advances in understanding its significance, contamination sources, and control strategies. Compr. Rev. Food Sci. Food Saf. 20(1), 738–786. Zanetti, S., Spanu, T., Deriu, A., Romano, L., Sechi, L.A. and Fadda, G. 2001. In vitro susceptibility of Vibrio spp. Isolated from the environment. Int. J. Antimicrob. Agents 17(5), 407–409. | ||
| How to Cite this Article |
| Pubmed Style Altayr NA, Bukha KK, Eteer SA, El-magrahi NA, Elhom AM, Elmaloul RA, Fakar SF. A comparative study to investigate foodborne pathogenic bacteria in fresh and imported frozen Scomber japonicus (Houttuyn, 1782) in Tripoli, Libya. Open Vet. J.. 2025; 15(4): 1607-1614. doi:10.5455/OVJ.2025.v15.i4.12 Web Style Altayr NA, Bukha KK, Eteer SA, El-magrahi NA, Elhom AM, Elmaloul RA, Fakar SF. A comparative study to investigate foodborne pathogenic bacteria in fresh and imported frozen Scomber japonicus (Houttuyn, 1782) in Tripoli, Libya. https://www.openveterinaryjournal.com/?mno=230591 [Access: January 24, 2026]. doi:10.5455/OVJ.2025.v15.i4.12 AMA (American Medical Association) Style Altayr NA, Bukha KK, Eteer SA, El-magrahi NA, Elhom AM, Elmaloul RA, Fakar SF. A comparative study to investigate foodborne pathogenic bacteria in fresh and imported frozen Scomber japonicus (Houttuyn, 1782) in Tripoli, Libya. Open Vet. J.. 2025; 15(4): 1607-1614. doi:10.5455/OVJ.2025.v15.i4.12 Vancouver/ICMJE Style Altayr NA, Bukha KK, Eteer SA, El-magrahi NA, Elhom AM, Elmaloul RA, Fakar SF. A comparative study to investigate foodborne pathogenic bacteria in fresh and imported frozen Scomber japonicus (Houttuyn, 1782) in Tripoli, Libya. Open Vet. J.. (2025), [cited January 24, 2026]; 15(4): 1607-1614. doi:10.5455/OVJ.2025.v15.i4.12 Harvard Style Altayr, N. A., Bukha, . K. K., Eteer, . S. A., El-magrahi, . N. A., Elhom, . A. M., Elmaloul, . R. A. & Fakar, . S. F. (2025) A comparative study to investigate foodborne pathogenic bacteria in fresh and imported frozen Scomber japonicus (Houttuyn, 1782) in Tripoli, Libya. Open Vet. J., 15 (4), 1607-1614. doi:10.5455/OVJ.2025.v15.i4.12 Turabian Style Altayr, Nouralhuday Ali, Khawla Khirallah Bukha, Shahrazad Ali Eteer, Najat Ali El-magrahi, Areeg M. Elhom, Rayan A. Elmaloul, and Salma F. Fakar. 2025. A comparative study to investigate foodborne pathogenic bacteria in fresh and imported frozen Scomber japonicus (Houttuyn, 1782) in Tripoli, Libya. Open Veterinary Journal, 15 (4), 1607-1614. doi:10.5455/OVJ.2025.v15.i4.12 Chicago Style Altayr, Nouralhuday Ali, Khawla Khirallah Bukha, Shahrazad Ali Eteer, Najat Ali El-magrahi, Areeg M. Elhom, Rayan A. Elmaloul, and Salma F. Fakar. "A comparative study to investigate foodborne pathogenic bacteria in fresh and imported frozen Scomber japonicus (Houttuyn, 1782) in Tripoli, Libya." Open Veterinary Journal 15 (2025), 1607-1614. doi:10.5455/OVJ.2025.v15.i4.12 MLA (The Modern Language Association) Style Altayr, Nouralhuday Ali, Khawla Khirallah Bukha, Shahrazad Ali Eteer, Najat Ali El-magrahi, Areeg M. Elhom, Rayan A. Elmaloul, and Salma F. Fakar. "A comparative study to investigate foodborne pathogenic bacteria in fresh and imported frozen Scomber japonicus (Houttuyn, 1782) in Tripoli, Libya." Open Veterinary Journal 15.4 (2025), 1607-1614. Print. doi:10.5455/OVJ.2025.v15.i4.12 APA (American Psychological Association) Style Altayr, N. A., Bukha, . K. K., Eteer, . S. A., El-magrahi, . N. A., Elhom, . A. M., Elmaloul, . R. A. & Fakar, . S. F. (2025) A comparative study to investigate foodborne pathogenic bacteria in fresh and imported frozen Scomber japonicus (Houttuyn, 1782) in Tripoli, Libya. Open Veterinary Journal, 15 (4), 1607-1614. doi:10.5455/OVJ.2025.v15.i4.12 |